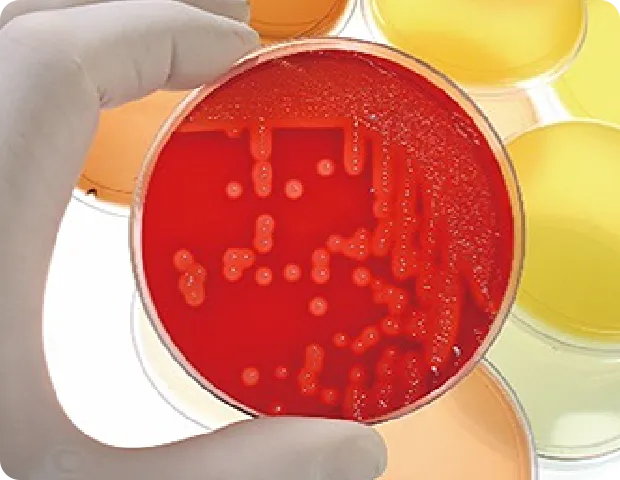
手袋をはめた手が赤い寒天培地を持っている。

分析・試験 リサーチ・コンサルティング
エネルギー
石油・石炭などの化石燃料から再生可能エネルギーまで、幅広い燃料の分析を行っています。
石炭・木炭・黒鉛・コークス・固形燃料
石炭、コークス等の固体燃料について、規格に準拠した工業分析・元素分析を行っています。一般性状分析をはじめ、各種試験・分析のニーズにお応えしています。


石油
ガソリン、灯油、ジェット燃料、SAF(航空燃料)、軽油、MGO(marine gas oil)、重油(VLSFO、A重油、C重油)、再生重油、原油、潤滑油、ナフサなど、石油製品はいずれも対応可能です。その他に、CBO(carbon black oil)、クレオソート油、コールタール、ピッチなども対応いたします。
規格試験は、JISはもとより JPI、ASTM、ISO、EN、IP、UOP、AOCSなどの海外規格にも対応しています。
通関分析(第27類〔塗料、潤滑油、スプレー〕、成分分析)も実施しております。
また、エンジンオイルの凍結試験等のメーカー指定の性能評価試験も各種対応可。オーダーメイドの試験も開発、実施いたします。



バイオマス燃料
化石燃料の代替燃料として様々なバイオマス・合成燃料が使われています。
固体燃料では木質ペレット、PKS、EFB、炭など、液体燃料ではBDF(FAME、UCOME)、SAF、HVO、廃食油・動植物油、その他油脂類、バイオナフサ、FT合成油、e-fuelなどがあり、これらの分析を実施しています。
規格試験では、ASTM D7566(SAF)、EN14214(FAME)など。さらに詳細な組成分析も実施いたします。



リサイクル燃料
プラスチック分解油、ゴム分解油、タイヤ分解油、再生油、熱分解油、廃油などのリサイクル燃料やRDF、RPF、汚泥などの固形燃料の分析を行っています。様々な視点から製品評価いたします。



ライフサイエンス
食品や化学品の原料など、日常生活に深くかかわる製品に関する分析を行っています。
化学品・化粧品原料
有機化学品(アルコール類、溶剤、グリセリン、エステル類、尿素水)、無機化学品(リン酸、硫酸、苛性カリ液)等の品質分析を行っております。国内外の試験法や規格に幅広く対応しています。

固体工業製品
塩・硫黄・ソーダ灰等の固体工業製品について、規格に準拠した分析を行っています。

食品分析
安全性を確認するための検査(放射能、重金属、残留農薬、カビ毒等)、表示に関わる検査(栄養成分、食品添加物(保存料・甘味料)、賞味期限等)など食品に係るあらゆる場面での検査に対応しています。
ISO/IEC17025:2017認定の放射能検査も対応可能です。



衛生コンサルティング(HACCP、ISO22000)
HACCPシステムの導入から検証・運用、衛生点検等の検査まで総合的にお手伝いいたします。
知識・技術水準の向上に向けた講習会の実施、規格(HACCP、ISO22000等)の取得支援や第三者評価も行っています。
肥料・飼料
肥料や飼料の栄養成分や安全性に係る成分(水分や粗蛋白等一般項目の他、メラミン、シアヌル酸、カビ毒、脂肪酸組成)の分析を行っています。
飼料分析基準、肥料等試験法に準拠した検査を行っています。

微生物検査
食品・添加物・化粧品・燃料油・土壌等、幅広い検体における各種検査(細菌、ウイルス、大腸菌、特定微生物限度試験)を実施し、あらゆる場面でのお客様のご要望にお応えします。
遺伝子検査
消費者庁通知法に基づくアレルギー検査や、遺伝子組換え食品の混入判定検査をはじめとした、分子生物学的手法を導入した食品・飼料の検査を実施しております。
ISO法によるカキ中のノロウイルス検査や、種同定(魚種、動物種)等も行っております。

リサイクル製品
金属系リサイクル製品の品質分析、成分分析を行っています。
スクラップ(有害金属)
様々な鉄鋼製品が使用後にスクラップとして回収され、再利用されています。弊会ではバーゼル法に係る有害物の分析やRoHS指令による規制物質の分析を行っています。



ブラックマス
ブラックマスは、使用済みリチウムイオン電池を処理することで得られる素材です。ブラックマスには有用金属であるリチウムやコバルト、ニッケル、銅、アルミニウムなどが含まれているため、再利用できる資源として注目されています。ブラックマス中に含まれるリチウムやコバルトなどの分析や、共存する不純物の分析を行っています。

ソーラーパネル
ソーラーパネルに含まれる有用金属(アルミニウム、銅、銀など)や有害金属(鉛、カドミウム、ヒ素、セレン)の測定を行っています。

金属・鉱石
金属、鉱石、非鉄金属、フェロアロイなどの原料・製品について湿式分析を中心に分析しています。
JIS、ISO、ASTM などに対応しています。
金属・合金鉄
合金鉄は、強度、靭性、耐熱性などの特性を高めるために鉄に添加される素材です。JIS規格に準拠した「湿式分析」を常時実施しています。更に、独自手法により様々なニーズにお応えしています。


非鉄金属製品
非鉄金属はセラミックスや貴金属、レアメタルなど、鉄を含まない金属です。規格の確認分析や不純物の分析などを行っています。


鉱石
鉄鉱石、シリカサンドなどは産業上有用な成分を多く含む資源です。これらの成分分析やX線回折による結晶構造の評価などを行っています。



試料調整
金属や鉱石などの分析は粉砕調整・前処理からはじまります。
ジョークラッシャー、全自動振動ミル、サンプルミル、遊星ボールミル(メノウ、タングステンカーバイト容器)、振動ミル(スチール、タングステンカーバイド)、ドリルなどのあらゆる試料調整器具を取り揃えています。 どのような試料調整でも対応可能ですので、お気軽にご相談下さい。


法律に係る試験・分析
各種規制・法律に沿った方法での試験・分析に対応しています。
液状化物質運送許容水分値測定(TML)
特殊貨物船舶運送規則第 17 条第 1 項では、「船長は、当該液状化物質の所在地を管轄する地方運輸局長又は登録検査機関が運送許容水分値(TML)及び水分(MC)の測定を行った液状化物質以外の液状化物質を船舶にばら積みして運送してはならない」と規定しています。 NKKKは、「登録検査機関」として液状化物質のTML及びMCの測定等を行っています。


危規則(危険物船舶運送及び貯蔵規則)
国連試験マニュアルに基づき、輸送における危険性評価を行っています。(引火性液体、可燃性固体、自己発熱性物質、酸化性物質、腐食性物質、火薬類、重合性物質など)
バーゼル法
バーゼル法は、特定有害廃棄物等の輸出、輸入、運搬、処分を規制することにより、環境保全を目的とした法律です。規制対象となっている物質の分析に対応しています。
WEEE指令・RoHS2指令
WEEE指令・RoHS2指令はともにEUで制定された、電気・電子機器による環境汚染の防止を目的とした法律です。各指令で対象とされている禁止・規制物質の分析を行っています。
消防法
消防法 第4類、第2類、アルコール類、指定可燃物の判定試験を行っています。
品確法 (揮発油等の品質の確保等に関する法律)
ガソリン(揮発油)、灯油、軽油、重油等の品確法の試験を行っています。
食品衛生法に係る検査・分析
対応している検査項目について、お気軽にお問い合わせください。
他の事例はこちら
技術資料
分析センターのご案内
当会分析センターでは、輸出入貨物や国内取引商品の品質、成分等が契約や規格に適合しているかどうかを証明するために、化学・物理試験ならびに食品衛生法および品確法に基づく検査を行います。
また、損害物品の損害の原因・程度を検査・調査・鑑定するために必要な資料として分析を行い、その結果について専門的意見を提供する国際総合分析機関です。
理化学分析センター
国土交通省登録検査機関
IMO IMSBC CODE(国際海上固体ばら積み貨物規則)に基づく液状化する貨物の運送許容水分値および密度の測定
経済産業大臣登録分析機関
「揮発油等の品質の確保等に関する法律」に基づく分析
食品衛生チーム
厚生労働大臣登録検査機関
食品衛生法に基づく検査・試験